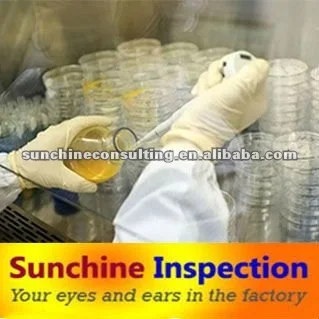
Quality control services: lab testing / inspection services / Factory Audits

Quality control services: lab testing / inspection services / Factory Audits
- Category: Certification, Inspection & Credit Management >>>
- Supplier: Nanjing Sunchine Quality Control Technology Service Co. Ltd. [Jiangsu China]Nanjing
Share on (609182838):
Product Overview
Description
Lab test/Inspection on Powdered Laundry detergent/washing Powder in Longkou
CHECK LIST:
Storage Condition
Quantity, package, marking, Random select package for Weight, and defectives.
Sealed with our Sunchine stickers and Sign
Send SAMPLES TO Lab for testing
LAB
Lab will perform testing after receiving samples
Accurate analysis report will be sent out after testing finishes






We are specialized and work exclusively on different metal parts and products that ensure our professional services as your Inspection Representatives.
|
Our Advantages |
1. One Multi-language team combined with Chinese and Western Expertise |
|
2.One Experienced Consultant/ Advisor Team+ Accredited Inspector Team |
|
|
3. Quick Reaction Service and on-line security payment system |
|
|
4. Assistance& Cooperation with other branch of sunchine International (Sunchine Consulting) |
|
|
5. Strict European Quality Standard for Inspection + Inspector selected according to product classification. |



In order to help you guarantee quality, we can provide a series of inspection process along producing,
|
Service Type |
1.Factory Inspections: |
|
Comprehensive assessment of the production facilities and organization according to ISO 9000 standard. Checking scope: make sure that company is true. Checking their all verified documents, and workshop, machine, work capacity, warehouse, quality control system and so on. Some time as client requirements, can check some sample quality, take sample and so on. |
|
|
2.Initial Production Check (IPC): |
|
|
Inspection of machinery and materials to be used for your order prior to production. |
|
|
3.First Article Inspection(FAI) |
|
|
Check and Verification of first sample from manufaturer compared with client's requirement for improving and planning the mass production |
|
|
4.Production Monitoring (PM): |
|
|
Constant oversight in your factory with daily reports on quality and production status. |
|
|
5.During Production Check (DUPRO) : |
|
|
Control and recommendations for production processes and capacity. |
|
|
6.Pre-Shipment Inspection (PSI) : |
|
|
An Inspection to guarantee the conformity of production to your specifications. Checking scope: quantity, quality, surface check, function test, packaging, label, bar code, carton quality and so on |
|
|
7.Container Loading Check (CLC): |
|
|
Guarantee the finished and packed goods meet your specifications (product type and quantity) and are securely loaded for shipment. Checking scope: account quantity, check container condition, make sure all goods will be load, and take photos about container number and seal number. |

We Recommend
New Arrivals
New products from manufacturers at wholesale prices